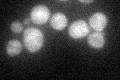
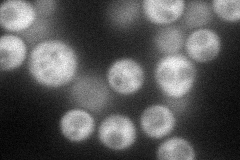
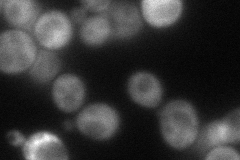
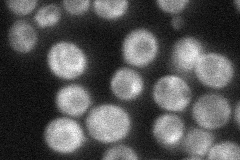
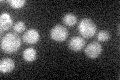

View description
Putative RNA binding protein and partially redundant Whi3p homolog that regulates the cell size requirement for passage through Start and commitment to cell division
Localization:
Intensity:
Fold change:
Significance:
-
C’ GFP library in SD
cytosol32.85 -
N' NOP1pr-GFP in SD
cytosol67.6636 -
N' TEF2pr-mCherry in SD
cytosol69.0003 -
N' NATIVEpr-GFP in SD
cytosol47.8805 -
N' TEF2pr-VC and Cyto-VN in SD

#N/A0 -
C’ GFP library in SD+DTT

cytosol33.991.03No -
C’ GFP library in SD+H2O2

cytosol34.971.06No -
C’ GFP library in Starvation Media
cytosol24.720.75No -
C’ GFP library on the background of Pup2-DaMP

cytosol -
C’ GFP library on the background of CCT mutant

cytosol35.0481.06653No
